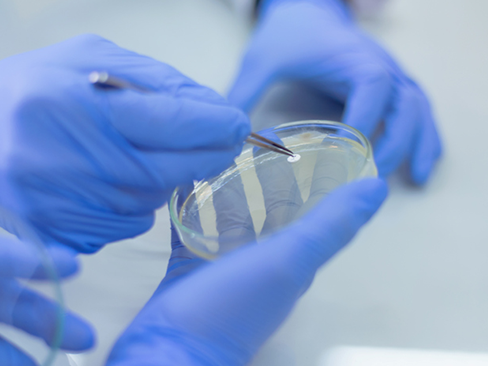
SEO

Somos Partner
Somos un Laboratorio de Cosmética para terceros, con años de experiencia en el sector, que avalan un producto de calidad.
En Bellcos, acompañamos y orientamos a cada cliente, durante todo el proceso creativo de sus proyectos.
Cuidamos cada detalle, en el desarrollo de fórmulas y producción ya sea con formulaciones propias o fabricación a partir de las fórmulas de nuestros clientes.